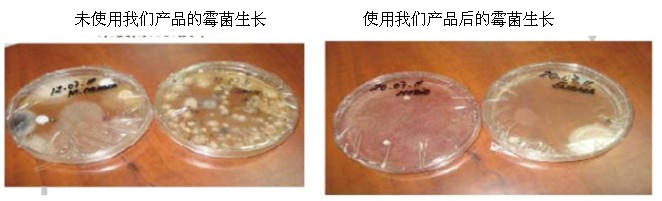

供应美国进口Activtek空气净化器

- 所在区域: 广东
- 价格范围: 电议
- 发布日期: 2014-10-28 04:31:45
- 有 效 期: 2015-10-27
- 供应数量: 1000
- 东莞市艾肯泰克净化科技有限公司
- 联 系 人: 庄清茹
- 电 话:
- 移动电话: 13528632575
- 传 真:
- 地 址: 长安镇新安社区横中路8号鹏达商务大厦6F
美国Activtek空气净化器是美国Activtek环境公司致力研究出来的。
美国activTek环境公司最早始建于1924年,隶属于美国DBG投资集团公司,是美国Aerus全资子公司。总部设在德克萨斯州的达拉斯,生产制造工厂设在弗吉尼亚州的布里斯托尔。
我们在业界率先将美国航天局发展和采用的光催化技术(催化电离辐射)商业化,加之我们长期不懈的科研攻关和所具备的一流空气净化设备,ActivTek收到了美国航空航天局下属的空间基金会颁发的空间技术认证证书,用以表彰我们自主研发的可消灭室内99%微生物的新技术。

市场上的净化器大多数以多级被动过滤为主,伴随着负离子除烟和臭氧杀菌。过滤式净化器的弱点是净化效率低,效果差,只能等含有烟气,异味,细菌,灰尘,装修污染物,花粉的空气通过净化器,它才能把它们过滤掉,没通过的就让它们自然消散,自生自灭,或继续残留于空气中,形成空气的二次污染。
ActivTek的产品和系统在亲近自然的基础上,整合了不同的生物科技,复制大自然净化空气的过程,来洁净室内空气,让您随时享受新鲜,清净的空气。
Activtek拥有新一代净化科技的卓越功能:
1-杀灭所有环境中的表面的微菌,细菌,病毒及霉菌,杜绝病源侵害人体。
2-高效分解甲醛,苯,氨,二氧化硫等有毒气体。
3-消除化学气味,臭味,香烟味等异味,提供清新洁净的空气环境。
4-清除烟雾,灰尘,尘螨,花粉和头屑等飘浮物,减少空气中各种过敏源。
四,来自美国国防部的嘉奖
事件回放;2001年9月11日早晨8:40恐怖分子劫机撞击位于纽约曼哈顿的世界贸易中心,一架袭击了首都华盛顿美国国防部所在地五角大楼。五角大楼遭到撞击后,局部受损,部分结构坍塌。
袭击事件令曼哈顿岛上空布满尘烟,五角大楼内部充斥的不良空气困扰,很多人咳嗽连连,连说话都感到费劲。
为了保障国防部大臣们的身体健康,也为了911事件的迅速妥善解决,国防部经过严格筛选,最后采用了经过美国太空基金会认证和堪萨斯大学,辛辛那提大学权威检测的全球一流产品,美国activTek空气净化机。
美国国防部认为,为感激美国activTek空气净化器为国防部大臣们提供了净化效果全方位的安全保障,特颁发嘉奖和感谢信。
艾肯泰克感谢您的支持! 庄小姐 13528632575

微信扫一扫更方便,
或是您可以直接登入我司网站http://activtek.b2b.hc360.com/
了解更多产品详情。
雾霾天气的多发,使得消费者越来越重视空气质量,各厂家也借机推出空气净化器产品,并在广告中宣称“PM2.5去除率99.99%”,“甲醛净化率99%”等。
但近日上海市消费者权利保护委员会对22台1488元至9300元不等的各品牌中高端型号空气净化器进行对比测试,测试结果却令人咋舌:只有两台样品甲醛净化效率达到97%,绝大部份大品牌涉嫌“虚假宣传”。
标称远大空品科技有限公司生产的“远大”牌,型号为TA400,价格为5880元的空气净化器产品甲醛净化效率仅为9%;
标称由上海乐扣乐扣贸易有限公司生产(或进口经销),品牌为LOCK&LOCK,型号为ELA-230C,价格为1580元的空气净化器产品该指标仅为8%。
不足20%的产品还包括:伊莱克斯Electrolux Z9123,福玛特 FMART APL100,HONEYWELL 18400,LG PH-U450WN,尚朋堂YS-360ACC等。
而高价位的夏普空气净化器(KJF420AA)甲醛净化效率仅61%,大金(MC70KMV2-R)实测值仅56%,三星(AC-347HPAWQ)与格力(KJG155A)实测值都仅为50%。
测试结果不免让消费者心寒。上海市环检站实验室主任,高级工程师沈浩指出,只要开窗通风,甲醛净化率也能达到50%。
所有样品的PM2.5净化效率只有两台真正达到宣传所称的“大于99%”。笔者对此解读为空气净化器的净化效果“水份太大”,而企业暴利也可由此窥一斑。究其原因,无非是净化器“国标”的缺失,企业诚信的丧失以及市场监督的缺位。相比节能,健康功能一直是家电产品的短板,这也是十余年来,健康空调,空气净化器等产品不愠不火的主因。
笔者认为,业内“虚假宣传”盛行,正是由于企业“犯错成本”过低所致。为此,笔者呼吁,相关标准制定部门,应尽快出台行业标准,以从根本上解决健康功能无据可依的局面;此外,建立有效的市场监督机制亦十分必要,一旦发现企业作假,应毫无留情的予以重罚,并以黑名单的方式进行曝光。
推荐您试一下 Activtek空气净化器,您值得信赖的空气净化器品牌。
http://activtek.b2b.hc360.com/
每次的雷雨天气之后,我们都会觉得空气特别清爽,新鲜。雨后的天气情况,空气质量让我们向往,一切事物都是很美妙的。
大自然利用闪电及降雨来净化空气,闪电会制造臭氧和能自然净化空气的正负离子,而降雨则是让这些臭氧及离子更贴近地球表面。之后,臭氧及离子会将空气中及地表上的污染物吸收或氧化。从而为我们打造了一个洁净的空气环境。
美国activTek空气净化器正是复制大自然净化空气的过程,来洁净室内空气,让您随时享受新鲜,清净的空气。
市场上的净化器大多数以多级被动过滤为主,伴随着负离子除烟和臭氧杀菌。过滤式净化器的弱点是净化效率低,效果差,只能等含有烟气,异味,细菌,灰尘,装修污染物,花粉的空气通过净化器,它才能把它们过滤掉,没通过的就让它们自然消散,自生自灭,或继续残留于空气中,形成空气的二次污染。
美国activTek空气净化器的主动净化技术和光氢离子技术,获得美国CERTIFIED SPACE TECHNOLOGY“航天技术认证”,与用来洁净太空舱内空气的科技相同。
Activtek 采用了美国太空总署NASA所运用于太空舱内净化空气的高科技ActivePure?/RCI先进技术,此科技为太空基金会认证的净化技术。并且获得美国绿色联盟组织成员资格,提供绿色环保的高科技空气净化产品。

美国进口Activtek空气净化器商品信息
公司名称:东莞市艾肯泰克净化科技有限公司 企业类型:经销商 经营模式:招商代理主营行业: 公司注册地址:广东 东莞 东莞市 法人代表:
员工人数:0 厂房面积: 年营业额:0
年进口额:0 年出口额:0 主要市场:中国大陆,香港,澳门区域
客户群:
联系方式:生产/研发空气净化器设备,家用空气净化器,工业空气净化器,臭氧发生器,空气检测仪器等。
公司名称:东莞市艾肯泰克净化科技有限公司 联系人:庄清茹 电话:--
移动电话:13528632575 传真:-- 地址:广东东莞东莞市长安镇新安社区横中路8号鹏达商务大厦6F
网址:http://activtek.bmlink.com
美国进口Activtek空气净化器产品概况
新奇饰品:NULL
东莞市艾肯泰克净化科技有限公司为您提供:供应美国进口Activtek空气净化器,供应美国进口Activtek空气净化器规格,批发供应美国进口Activtek空气净化器,供应美国进口Activtek空气净化器使用方法,供应美国进口Activtek空气净化器注意事项,供应美国进口Activtek空气净化器产品说明等相关信息,欢迎您的咨询和查看。







